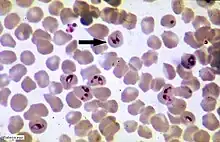

piroplasma
English
A typical piroplasma: pear-shaped cells of a Babesia species infecting the blood cells of a horse
Alternative forms
Etymology
From Latin pirum (“pear”) + Ancient Greek πλάσμα (plásma, “image, formation”).
Noun
piroplasma (plural piroplasmas or piroplasmata)
- (epidemiology, microbiology) Babesia, a genus of hematozoa that invades the red blood cells of humans and domesticated animals such as dogs and sheep
- Any of many other parasitic protozoa related to Babesia in order Piroplasmida
- 2011, Jan Votýpka, Piroplasmorida, Tree of Life Web Project:[1]
- Present systematics of piroplasms is based almost entirely upon criteria derived from taxonomic interpretation of a combination of morphology of the intraerythrocytic stages, host specificity, vector, mode of pathogenesis and pathogenicity, cross-immunity, frequency of schizonts and piroplasms, and spatial distribution
Related terms
References
- Votýpka, Jan. 2011. Piroplasmorida Wenyon 1926. Version 18 May 2011 (under construction). in The Tree of Life Web Project, http://tolweb.org/
Further reading
- “piroplasma”, in OneLook Dictionary Search.
piroplasma on Wikipedia.Wikipedia
This article is issued from Wiktionary. The text is licensed under Creative Commons - Attribution - Sharealike. Additional terms may apply for the media files.